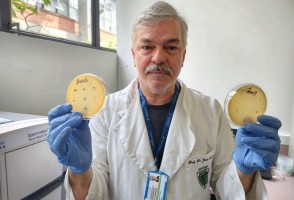
Scientists identify 62 new viruses with the potential for biological control
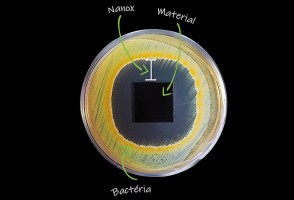
CDMF spin-off company wins award at the BRICS Solutions Awards 2025

Study reveals how giant trees in tropical forests transport water to their uppermost branches
The study published in Science helps us understand the role of this little-studied type of vegetation in climate change. One percent of the tallest trees store more than half of the carbon in tropical forest ecosystems.
New device advances computing that mimics the human brain
In systems inspired by neural networks and synapses, an oxide-based structure combines processing and memory into a single component, with the potential to reduce energy consumption and increase efficiency.
São Paulo to host country’s first plant for capturing and storing carbon from sugarcane ethanol
The initiative, estimated to cost BRL 30 million, brings together FAPESP, the University of São Paulo, the State Department for the Environment, and the productive sector.

New metal alloy can be used for orthopedic implants and aircraft components
The 3D-printed, titanium-based multilayer structure combines two generally contradictory properties: strength and ductility.
Storms impact the architecture of webs and the survival of spiders
Study conducted in the Ecuatorian Andes shows how heavy rains damage these silk-weaved traps and act as a kind of “ecological filter” for spider species.
The Center for Research in Mental Health creates public policy support unit
The new unit will focus on data science, neuroscience, population-based epidemiology, and mental healthcare for children, adolescents, and young adults.
Over the past 15 years, Brazil has seen a more than 200% increase in non-native mollusk species
Data from nearly the entire country indicates that the number of species rose from 26 to 82 between 2011 and 2025, in addition to 13 species of unknown origin. The authors highlight the need to strengthen biosecurity and early detection measures, as well as long-term monitoring programs, to improve our understanding of the impacts.

New center will assess the impact of music on the mental health of young people and adolescents
Based in the city of São Paulo, the Interdisciplinary Center for the Development of Music Research is a partnership between FAPESP, São Paulo State University, and the Department of Creative Culture, Economy, and Industry.
Diabetes worsens long COVID complications
In a study by the University of São Paulo involving 870 participants, people with diabetes took longer to recover from the virus and experienced more severe cardiac complications, as well as greater physical and cognitive difficulties.
Data intelligence predicts water shortages in rural areas
FAPESP-backed startup forecasts water availability from springs to support decision-making in scenarios of irregular rainfall.
Use of supplement before surgery improves liver regeneration
In an experimental study conducted at the State University of Campinas, the livers of animals that were supplemented with HMB showed less damage and functioned better when subjected to new stress.